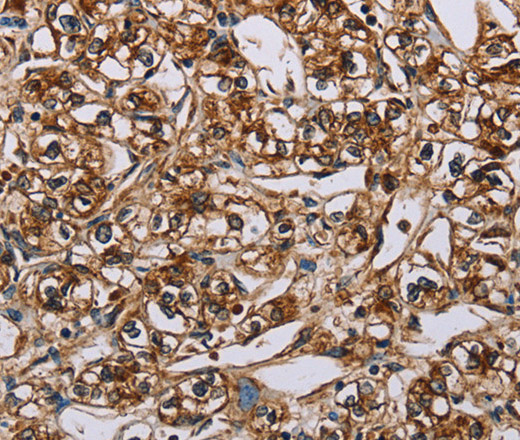
Валидация Elabscience E-AB-13093

| UNIPROT | P22004 |
| Иммуноген | Синтетический пептид, соответствующий человеческому BMP6 |
BMP6 Polyclonal Antibody (E-AB-13093)
Реактивность подтвержденная:
человек, мышь, крыса
Источник (хозяин):
кролик
Валидировано для:
IHC
WB
Характеристики
Техническое описание
| Каталожный номер | E-AB-13093 |
| Название антигена | Bone Morphogenetic Protein 6 (BMP6) |
| UNIPROT | P22004 |
| Иммуноген | Синтетический пептид, соответствующий человеческому BMP6 |
| Английские синонимы | VGR, VGR1, Vegetal Related Growth Factor(TGFB-Related), VG-1-related protein |
Реактивность подтвержденная Нужна другая реактивность? |
человек, мышь, крыса |
| Источник (хозяин) | кролик |
| Изотип | IgG |
| Клональность | поликлональное |
| Рекомбинантное | нет |
| Готовое к использованию | нет |
| Концентрация | 1 мг/мл |
| Конъюгат | нет |
| Валидировано для | IHC WB Иммуногистохимия; Вестерн-блоттинг |
| Рекомендуемые разведения | WB 1:500-1:2000; IHC 1:50-1:200 |
| Метод очистки | Аффинная хроматография |
| Состав буфера | PBS с 0.05% азид натрия и 50% глицерин, PH7.4 |
| RRID | AB_533234 |
| Условия доставки | термобокс с аккумуляторами холода |
| Условия хранения | Хранить при -20°C - 12 месяцев. Избегать повторяющихся циклов замораживания/оттаивания |
| Срок хранения | 12 месяцев |
| Производитель | Elabscience |
| Ссылка на страницу товара на сайте производителя | https://www.elabscience.com/p-bmp6_polyclonal_antibody-e_ab_13093 |
|
Артикул
|
Наименование |
Производитель
|
|---|
|
Артикул
|
Наименование |
Производитель
|
|---|
|
Артикул
|
Наименование |
Производитель
|
|---|
|
Артикул
|
Наименование |
Производитель
|
|---|
|
Артикул
|
Наименование |
Производитель
|
|---|
Акции и предложения
Популярные продукты:
Anti-HEV ORF3 Antibody (SAb2337) (RVV45601)
Источник (хозяин): человек
Реактивность подтвержденная: вирусы
Валидировано для: ELISA, IF, WB
Реактивность подтвержденная: вирусы
Валидировано для: ELISA, IF, WB
Anti-Cyclophilin A (CYPA) Polyclonal Antibody (FAA979Po01)
Источник (хозяин): кролик
Реактивность подтвержденная: свинья
Валидировано для: WB
Реактивность подтвержденная: свинья
Валидировано для: WB
ELISA Kit DIY Materials for Nucleosome Assembly Protein 1 Like Protein 1 (NAP1L1) (KSH571Hu01)
Организм: человек
Диапазон определения: 0.312-20 нг/мл
Чувствительность: 0.119 нг/мл
Диапазон определения: 0.312-20 нг/мл
Чувствительность: 0.119 нг/мл
ELISA Kit DIY Materials for Nerve Growth Factor (NGF) (KSA105Gu01)
Организм: морская свинка
Диапазон определения: 15.6-1000 пг/мл
Чувствительность: 5.9 пг/мл
Диапазон определения: 15.6-1000 пг/мл
Чувствительность: 5.9 пг/мл
Guinea Pig Lactic Acid ELISA kit (E05L0004)
Организм: морская свинка